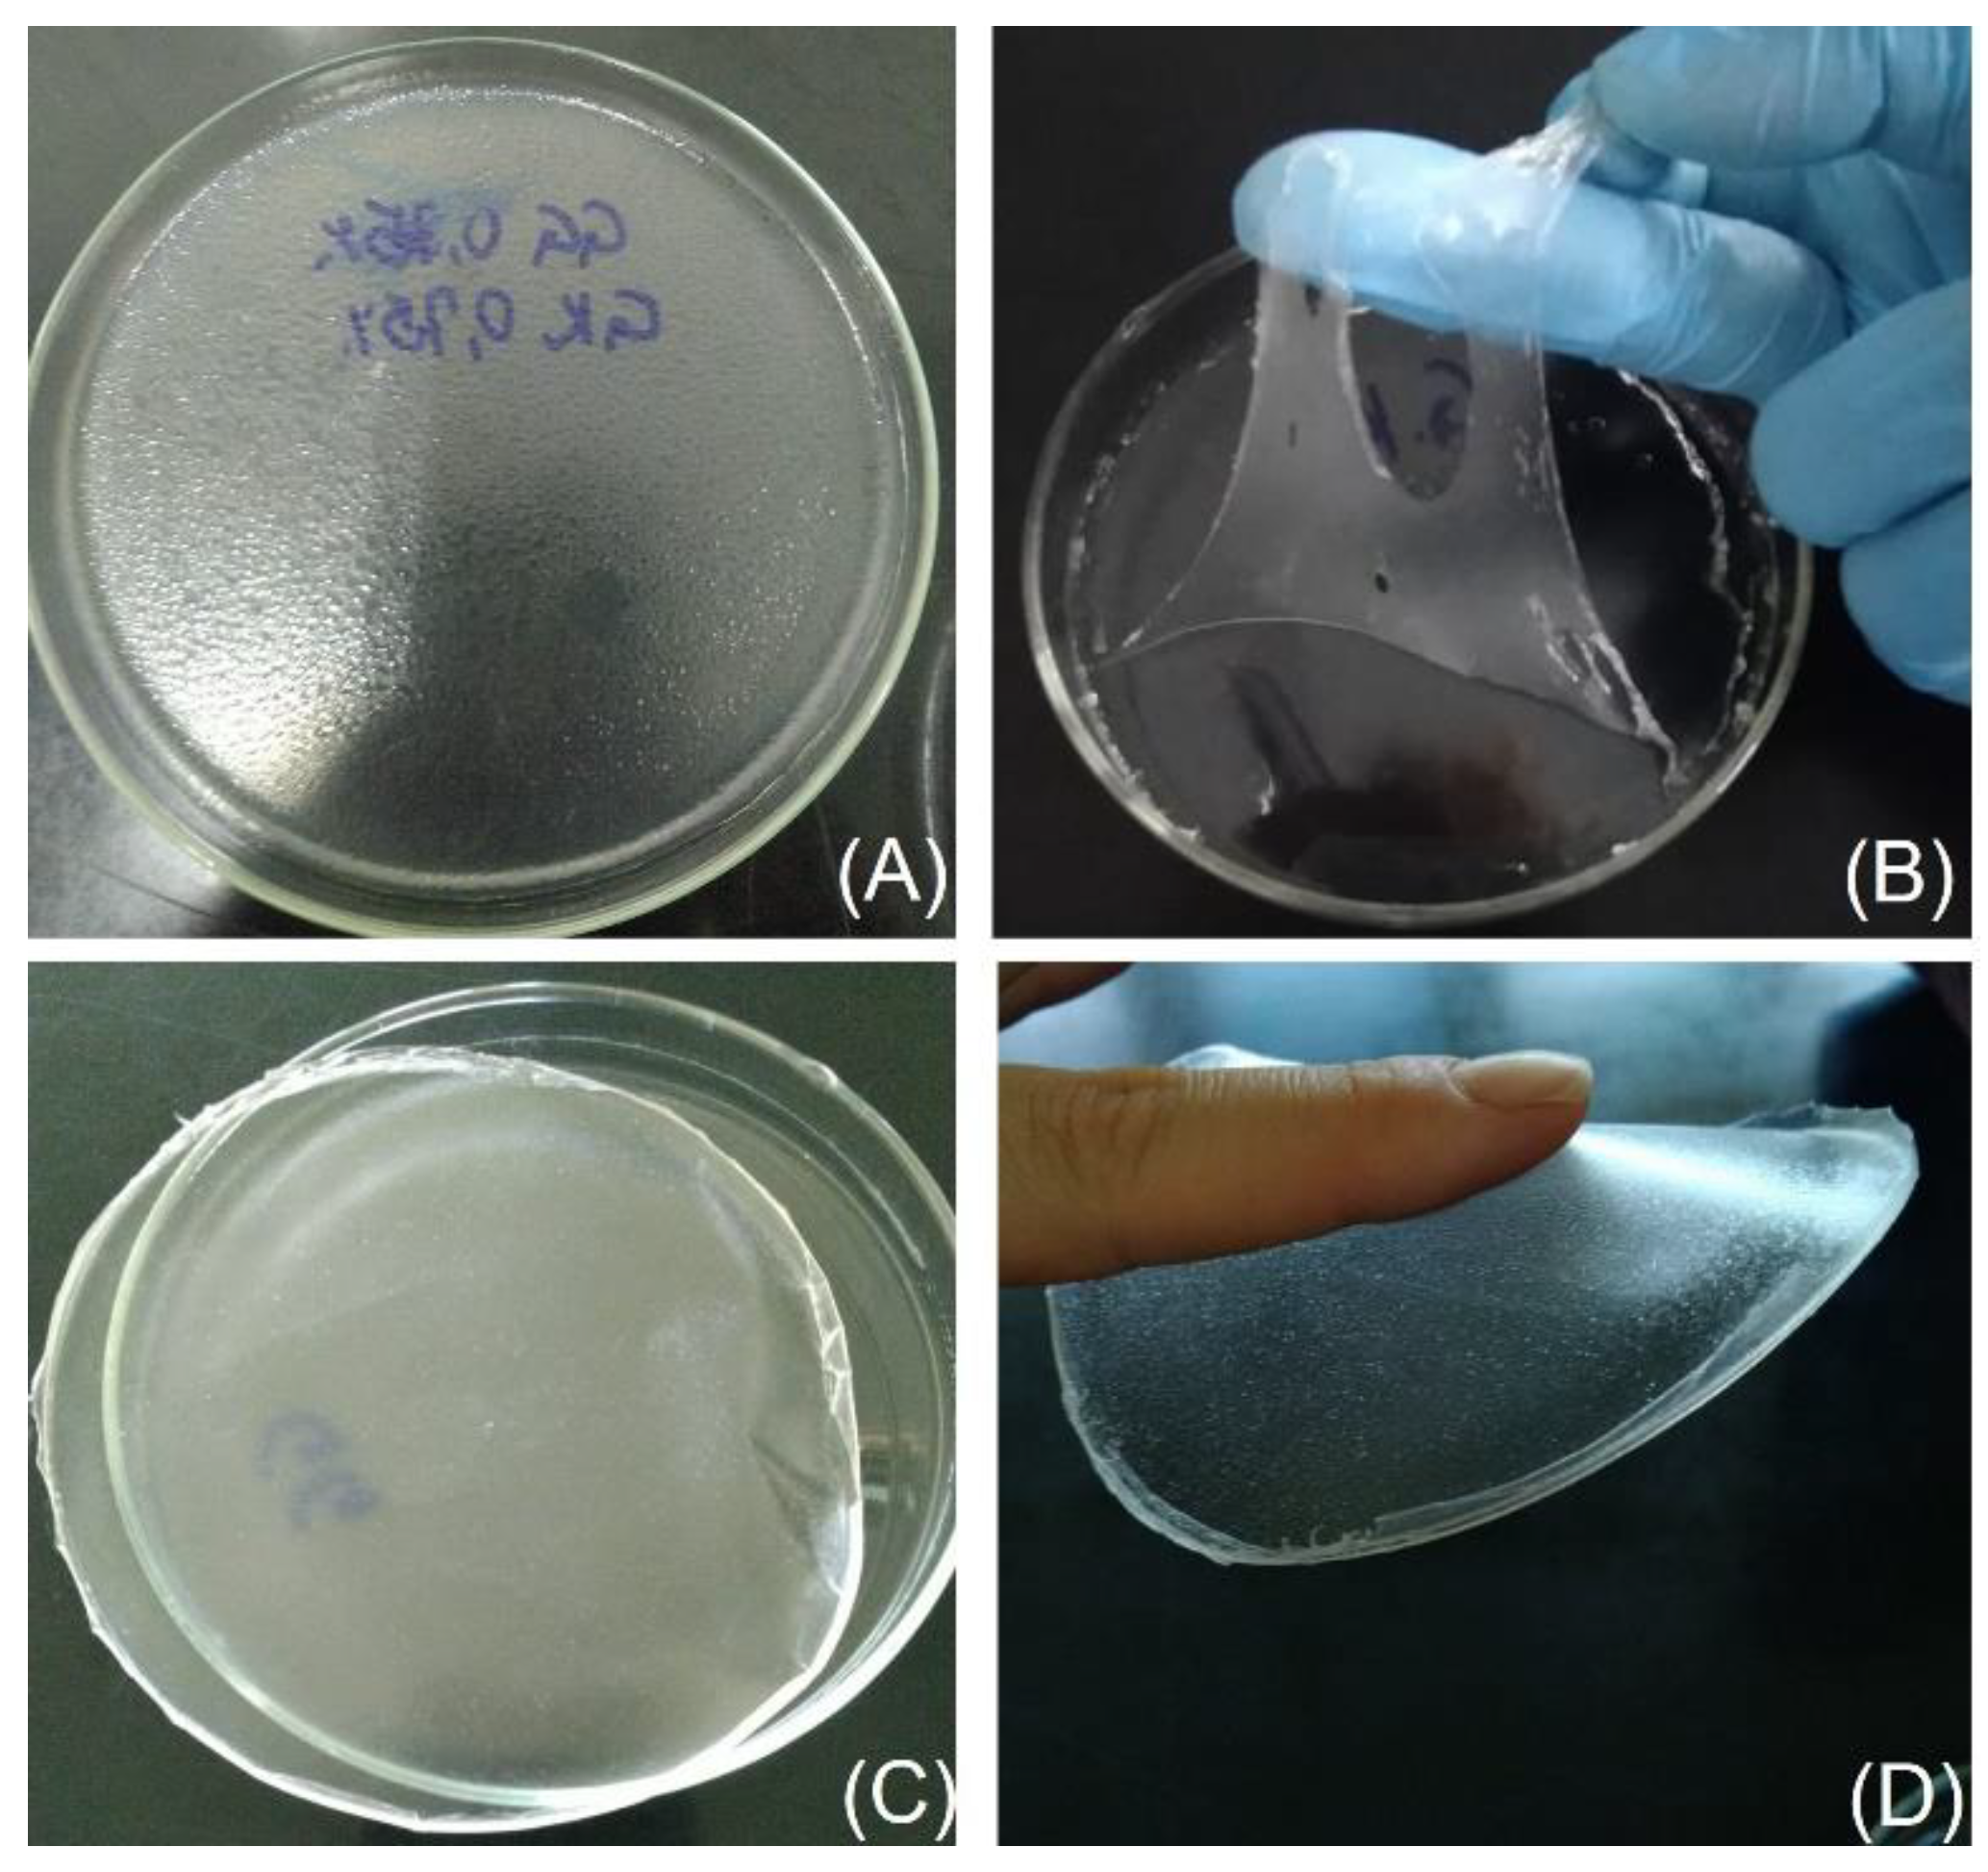
Pharmaceutics 15 02234 g001

Karaya/Gellan-Gum-Based Bilayer Films Containing 3,3′-Diindolylmethane-Loaded Nanocapsules: A Promising Alternative to Melanoma Topical Treatment
Abstract
:1. Introduction
2. Materials and Methods
2.1. Reagents
2.2. Analytical Procedures
2.3. Preparation and Characterization of Nanocapsule Suspensions
2.4. In Vitro Antitumoral Assay
2.5. Preparation of Bilayer Films
2.6. Films Characterization
2.7. Scanning Electron Microscopy
2.8. Mechanical Properties
2.9. Water Contact Angle
2.10. Swelling Index
2.11. Bioadhesive Strength
2.12. In Vitro DIM Release
2.13. DIM Skin Permeation/Penetration Study
2.14. Antioxidant Activity
2.15. Biocompatibility Assays
2.16. Statistical Analyses
3. Results and Discussion
3.1. Preparation and Characterization of Nanocapsule Suspensions
3.2. In Vitro Antitumoral Activity
3.3. Pre-Formulation Studies
3.4. Film Characterization
3.5. Scanning Electron Microscopy
3.6. Mechanical Properties
3.7. Water Contact Angle
3.8. Swelling Index
3.9. Bioadhesive Strength
3.10. In Vitro DIM Release
3.11. DIM Skin Permeation/Penetration Study
3.12. Antioxidant Activity
3.13. Biocompatibility Tests
4. Conclusions
Author Contributions
Funding
Institutional Review Board Statement
Informed Consent Statement
Data Availability Statement
Acknowledgments
Conflicts of Interest
References
- Sadozai, H.; Gruber, T.; Hunger, R.E.; Schenk, M. Recent Successes and Future Directions in Immunotherapy of Cutaneous Melanoma. Front. Immunol. 2017, 8, 1617. [Google Scholar] [CrossRef] [PubMed]
- Oca, M.K.M.; Pearlman, R.L.; Mccless, S.F.; Strickland, R.; Afaq, F. Phytochemicals for the Prevention of Photocarcinogenesis. Int. J. Lab. Hematol. 2016, 38, 42–49. [Google Scholar] [CrossRef]
- Leonardi, G.C.; Falzone, L.; Salemi, R.; Zanghì, A.; Spandidos, D.A.; Mccubrey, J.A.; Candido, S.; Libra, M. Cutaneous Melanoma: From Pathogenesis to Therapy (Review). Int. J. Oncol. 2018, 52, 1071–1080. [Google Scholar] [CrossRef] [PubMed]
- Rigon, R.B.; Oyafuso, M.H.; Fujimura, A.T.; Gonçalez, M.L.; Do Prado, A.H.; Gremião, M.P.D.; Chorilli, M. Nanotechnology-Based Drug Delivery Systems for Melanoma Antitumoral Therapy: A Review. Biomed Res. Int. 2015, 2015, 16–20. [Google Scholar] [CrossRef] [PubMed]
- Thomson, C.A.; Chow, H.H.S.; Wertheim, B.C.; Roe, D.J.; Stopeck, A.; Maskarinec, G.; Altbach, M.; Chalasani, P.; Huang, C.; Strom, M.B.; et al. A Randomized, Placebo-Controlled Trial of Diindolylmethane for Breast Cancer Biomarker Modulation in Patients Taking Tamoxifen. Breast Cancer Res. Treat. 2017, 165, 97–107. [Google Scholar] [CrossRef] [PubMed]
- Amare, D.E. Anti-Cancer and Other Biological Effects of a Dietary Compound 3,3ʹ-Diindolylmethane Supplementation: A Systematic Review of Human Clinical Trials. Nutr. Diet. Suppl. 2020, 12, 123–137. [Google Scholar] [CrossRef]
- Heo, J.R.; Lee, G.A.; Kim, G.S.; Hwang, K.A.; Choi, K.C. Phytochemical-Induced Reactive Oxygen Species and Endoplasmic Reticulum Stress-Mediated Apoptosis and Differentiation in Malignant Melanoma Cells. Phytomedicine 2018, 39, 100–110. [Google Scholar] [CrossRef]
- Hwang, C.; Sethi, S.; Heilbrun, L.K.; Gupta, N.S.; Chitale, D.A.; Sakr, W.A.; Menon, M.; Peabody, J.O.; Smith, D.W.; Sarkar, F.H.; et al. Anti-Androgenic Activity of Absorption-Enhanced 3, 3’-Diindolylmethane in Prostatectomy Patients. Am. J. Transl. Res. 2016, 8, 166–176. [Google Scholar]
- Wang, X.; Zhao, Y.; Yu, M.; Xu, Y. PTEN/Akt Signaling-Mediated Activation of the Mitochondrial Pathway Contributes to the 3,3′-Diindolylmethane-Mediated Antitumor Effect in Malignant Melanoma Cells. J. Med. Food 2020, 23, 1248–1258. [Google Scholar] [CrossRef]
- Patel, A.R.; Spencer, S.D.; Chougule, M.B.; Safe, S.; Singh, M. Pharmacokinetic Evaluation and In Vitro-In Vivo Correlation (IVIVC) of Novel Methylene-Substituted 3,3′ Diindolylmethane (DIM). Eur. J. Pharm. Sci. 2012, 46, 8–16. [Google Scholar] [CrossRef]
- Wu, T.; Chen, C.; Li, F.; Chen, Z.; Xu, Y.; Xiao, B.; Tao, Z. 3,3′-Diindolylmethane Inhibits the Invasion and Metastasis of Nasopharyngeal Carcinoma Cells In Vitro and In Vivo by Regulation of Epithelial Mesenchymal Transition. Exp. Ther. Med. 2014, 7, 1635–1638. [Google Scholar] [CrossRef] [PubMed]
- Bruxel, F.; Laux, M.; Wild, L.B.; Fraga, M.; Koester, L.S.; Teixeira, H.F. Nanoemulsions as Prospective Drug Delivery Systems. Quim. Nova 2012, 35, 1827–1840. [Google Scholar] [CrossRef]
- Luo, Y.; Wang, T.T.Y.; Teng, Z.; Chen, P.; Sun, J.; Wang, Q. Encapsulation of Indole-3-Carbinol and 3,3′-Diindolylmethane in Zein/Carboxymethyl Chitosan Nanoparticles with Controlled Release Property and Improved Stability. Food Chem. 2013, 139, 224–230. [Google Scholar] [CrossRef] [PubMed]
- Khan, A.; Wang, C.; Sun, X.; Killpartrick, A.; Guo, M. Preparation and Characterization of Whey Protein Isolate–Dim Nanoparticles. Int. J. Mol. Sci. 2019, 20, 3917. [Google Scholar] [CrossRef] [PubMed]
- Mattiazzi, J.; Sari, M.H.M.; Lautenchleger, R.; Dal Prá, M.; Braganhol, E.; Cruz, L. Incorporation of 3,3′-Diindolylmethane into Nanocapsules Improves Its Photostability, Radical Scavenging Capacity, and Cytotoxicity Against Glioma Cells. AAPS PharmSciTech 2019, 20, 49. [Google Scholar] [CrossRef] [PubMed]
- Carter, P.; Narasimhan, B.; Wang, Q. Biocompatible Nanoparticles and Vesicular Systems in Transdermal Drug Delivery for Various Skin Diseases. Int. J. Pharm. 2019, 555, 49–62. [Google Scholar] [CrossRef]
- Gupta, S.; Bansal, R.; Gupta, S.; Jindal, N.; Jindal, A. Nanocarriers and Nanoparticles for Skin Care and Dermatological Treatments. Indian Dermatol. Online J. 2013, 4, 267. [Google Scholar] [CrossRef] [PubMed]
- Casarini, T.P.A.; Frank, L.A.; Benin, T.; Onzi, G.; Pohlmann, A.R.; Guterres, S.S. Innovative Hydrogel Containing Polymeric Nanocapsules Loaded with Phloretin: Enhanced Skin Penetration and Adhesion. Mater. Sci. Eng. C 2021, 120, 111681. [Google Scholar] [CrossRef]
- Xu, H.; Wen, Y.; Chen, S.; Zhu, L.; Feng, R.; Song, Z. Paclitaxel Skin Delivery by Micelles-Embedded Carbopol 940 Hydrogel for Local Therapy of Melanoma. Int. J. Pharm. 2020, 587, 119626. [Google Scholar] [CrossRef]
- Barone, A.; Mendes, M.; Cabral, C.; Mare, R.; Paolino, D.; Vitorino, C. Hybrid Nanostructured Films for Topical Administration of Simvastatin as Coadjuvant Treatment of Melanoma. J. Pharm. Sci. 2019, 108, 3396–3407. [Google Scholar] [CrossRef]
- Deng, S.; Gigliobianco, M.R.; Censi, R.; Di Martino, P. Polymeric Nanocapsules as Nanotechnological Alternative for Drug Delivery System: Current Status, Challenges and Opportunities. Nanomaterials 2020, 10, 847. [Google Scholar] [CrossRef] [PubMed]
- Bhowmik, A.; Chakravarti, S.; Ghosh, A.; Shaw, R.; Bhandary, S.; Bhattacharyya, S.; Sen, P.C.; Ghosh, M.K. Anti-SSTR2 Peptide Based Targeted Delivery of Potent PLGA Encapsulated 3,3’-Diindolylmethane Nanoparticles through Blood Brain Barrier Prevents Glioma Progression. Oncotarget 2017, 8, 65339–65358. [Google Scholar] [CrossRef] [PubMed]
- Michels, L.R.; Maciel, T.R.; Nakama, K.A.; Teixeira, F.E.G.; de Carvalho, F.B.; Gundel, A.; de Araujo, B.V.; Haas, S.E. Effects of Surface Characteristics of Polymeric Nanocapsules on the Pharmacokinetics and Efficacy of Antimalarial Quinine. Int. J. Nanomedicine 2019, 14, 10165–10178. [Google Scholar] [CrossRef] [PubMed]
- Gehrcke, M.; de Bastos Brum, T.; da Rosa, L.S.; Ilha, B.D.; Soares, F.Z.M.; Cruz, L. Incorporation of Nanocapsules into Gellan Gum Films: A Strategy to Improve the Stability and Prolong the Cutaneous Release of Silibinin. Mater. Sci. Eng. C 2021, 119, 111624. [Google Scholar] [CrossRef]
- Ferrari Cervi, V.; Parcianello Saccol, C.; Henrique Marcondes Sari, M.; Cristóvão Martins, C.; Saldanha da Rosa, L.; Dias Ilha, B.; Zovico Soares, F.; Luchese, C.; Antunes Wilhelm, E.; Cruz, L. Pullulan Film Incorporated with Nanocapsules Improves Pomegranate Seed Oil Anti-Inflammatory and Antioxidant Effects in the Treatment of Atopic Dermatitis in Mice. Int. J. Pharm. 2021, 609, 121114. [Google Scholar] [CrossRef] [PubMed]
- Giacomeli, R.; de Gomes, M.G.; Reolon, J.B.; Haas, S.E.; Colomé, L.M.; Jesse, C.R. Chrysin Loaded Lipid-Core Nanocapsules Ameliorates Neurobehavioral Alterations Induced by β-Amyloid1-42 in Aged Female Mice. Behav. Brain Res. 2020, 390, 112696. [Google Scholar] [CrossRef] [PubMed]
- Ferreira, L.M.; Cervi, V.F.; Gehrcke, M.; da Silveira, E.F.; Azambuja, J.H.; Braganhol, E.; Sari, M.H.M.; Zborowski, V.A.; Nogueira, C.W.; Cruz, L. Ketoprofen-Loaded Pomegranate Seed Oil Nanoemulsion Stabilized by Pullulan: Selective Antiglioma Formulation for Intravenous Administration. Colloids Surf. B Biointerfaces 2015, 130, 272–277. [Google Scholar] [CrossRef]
- Amri, Z.; Lazreg-Aref, H.; Mekni, M.; El-Gharbi, S.; Dabbaghi, O.; Mechri, B.; Hammami, M. Oil Characterization and Lipids Class Composition of Pomegranate Seeds. Biomed Res. Int. 2017, 2017, 1–8. [Google Scholar] [CrossRef]
- Beber, T.C.; De Andrade, D.F.; Dos Santos Chaves, P.; Pohlmann, A.R.; Guterres, S.S.; Ruver Beck, R.C. Cationic Polymeric Nanocapsules as a Strategy to Target Dexamethasone to Viable Epidermis: Skin Penetration and Permeation Studies. J. Nanosci. Nanotechnol. 2016, 16, 1331–1338. [Google Scholar] [CrossRef]
- Cardoso, A.M.; De Oliveira, E.G.; Bruinsmann, F.A.; Aguirre, T.; Cristiane, R.; Barcelos, S.; Roversi, K.; Rossato, D.R.; Pohlmann, A.R.; Guterres, S.; et al. Chitosan Hydrogels Containing Nanoencapsulated Phenytoin for Cutaneous Use: Skin Permeation/Penetration and Efficacy in Wound Healing. Mater. Sci. Eng. C 2018, 96, 205–217. [Google Scholar] [CrossRef]
- Gazzi, R.P.; Frank, L.A.; Onzi, G.; Pohlmann, A.R.; Guterres, S.S. New Pectin-Based Hydrogel Containing Imiquimod-Loaded Polymeric Nanocapsules for Melanoma Treatment. Drug Deliv. Transl. Res. 2020, 10, 1829–1840. [Google Scholar] [CrossRef] [PubMed]
- Ferreira, L.M.; Sari, M.H.M.; Azambuja, J.H.; da Silveira, E.F.; Cervi, V.F.; Marchiori, M.C.L.; Maria-Engler, S.S.; Wink, M.R.; Azevedo, J.G.; Nogueira, C.W.; et al. Xanthan Gum-Based Hydrogel Containing Nanocapsules for Cutaneous Diphenyl Diselenide Delivery in Melanoma Therapy. Investig. New Drugs 2020, 38, 662–674. [Google Scholar] [CrossRef]
- Karki, S.; Kim, H.; Na, S.J.; Shin, D.; Jo, K.; Lee, J. Thin Films as an Emerging Platform for Drug Delivery. Asian J. Pharm. Sci. 2016, 11, 559–574. [Google Scholar] [CrossRef]
- Contardi, M.; Ayyoub, A.M.M.; Summa, M.; Kossyvaki, D.; Fadda, M.; Liessi, N.; Armirotti, A.; Fragouli, D.; Bertorelli, R.; Athanassiou, A. Self-Adhesive and Antioxidant Poly(Vinylpyrrolidone)/Alginate-Based Bilayer Films Loaded with Malva Sylvestris Extracts as Potential Skin Dressings. ACS Appl. Bio Mater. 2022, 5, 2880–2893. [Google Scholar] [CrossRef] [PubMed]
- Padula, C.; Nicoli, S.; Pescina, S.; Santi, P. Thin Polymeric Films for the Topical Delivery of Propranolol. Colloids Surf. B Biointerfaces 2019, 174, 582–586. [Google Scholar] [CrossRef]
- Contardi, M.; Russo, D.; Suarato, G.; Heredia-Guerrero, J.A.; Ceseracciu, L.; Penna, I.; Margaroli, N.; Summa, M.; Spanò, R.; Tassistro, G.; et al. Polyvinylpyrrolidone/Hyaluronic Acid-Based Bilayer Constructs for Sequential Delivery of Cutaneous Antiseptic and Antibiotic. Chem. Eng. J. 2019, 358, 912–923. [Google Scholar] [CrossRef]
- Gehrcke, M.; Martins, C.C.; de Bastos Brum, T.; da Rosa, L.S.; Luchese, C.; Wilhelm, E.A.; Soares, F.Z.M.; Cruz, L. Novel Pullulan/Gellan Gum Bilayer Film as a Vehicle for Silibinin-Loaded Nanocapsules in the Topical Treatment of Atopic Dermatitis. Pharmaceutics 2022, 14, 2352. [Google Scholar] [CrossRef]
- Sari, M.H.M.S.; Mota Ferreira, L.; Cruz, L. The Use of Natural Gums to Produce Nano-Based Hydrogels and Films for Topical Application. Int. J. Pharm. 2022, 626, 122166. [Google Scholar] [CrossRef]
- Tsai, W.; Tsai, H.; Wong, Y.; Hong, J.; Chang, S.; Lee, M. Preparation and Characterization of Gellan Gum/Glucosamine/Clioquinol Film as Oral Cancer Treatment Patch. Mater. Sci. Eng. C 2018, 82, 317–322. [Google Scholar] [CrossRef]
- Mahmood, H.; Khan, I.U.; Asif, M.; Khan, R.U.; Asghar, S.; Khalid, I.; Khalid, S.H.; Irfan, M.; Rehman, F.; Shahzad, Y.; et al. In Vitro and in Vivo Evaluation of Gellan Gum Hydrogel Films: Assessing the Co Impact of Therapeutic Oils and Ofloxacin on Wound Healing. Int. J. Biol. Macromol. 2021, 166, 483–495. [Google Scholar] [CrossRef]
- Ismail, N.A.; Amin, K.A.M.; Majid, F.A.A.; Razali, M.H. Gellan Gum Incorporating Titanium Dioxide Nanoparticles Biofilm as Wound Dressing: Physicochemical, Mechanical, Antibacterial Properties and Wound Healing Studies. Mater. Sci. Eng. C 2019, 103, 109770. [Google Scholar] [CrossRef]
- Raj, V.; Lee, J.; Shim, J.; Lee, J. Recent Findings and Future Directions of Grafted Gum Karaya Polysaccharides and Their Various Applications: A Review. Carbohydr. Polym. 2021, 258, 117687. [Google Scholar] [CrossRef] [PubMed]
- Bera, H.; Abbasi, Y.F.; Hasnain, S.; Nayak, A.K. Chapter 9—Sterculia Gum in Drug Delivery Applications; Elsevier Inc.: Amsterdam, The Netherlands, 2019; ISBN 9780128170557. [Google Scholar]
- Martín-illana, A.; Chinarro, E.; Cazorla-luna, R.; Notario-perez, F.; Veiga-ochoa, D.; Rubio, J.; Tamayo, A. Optimized Hydration Dynamics in Mucoadhesive Xanthan-Based Trilayer Vaginal Films for the Controlled Release of Tenofovir. Carbohydr. Polym. 2022, 278, 118958. [Google Scholar] [CrossRef] [PubMed]
- Patel, A.; Patel, N.; Shah, D. In Vitro and In Vivo Evaluation of Chitosan/Karaya Gum Interpolymer Complex Based Mucoadhesive Buccal Films of Tramadol HCl. Asian J. Pharm. 2017, 11, 3–11. [Google Scholar] [CrossRef]
- Drápalová, E.; Michlovská, L.; Poštulková, H.; Chamradová, I.; Lipový, B.; Holoubek, J.; Vacek, L.; Růžička, F.; Hanslianová, M.; Svobodová, T.; et al. Antimicrobial Cost-Effective Transparent Hydrogel Films from Renewable Gum Karaya/Chitosan Polysaccharides for Modern Wound Dressings. ACS Appl. Polym. Mater. 2023, 5, 2774–2786. [Google Scholar] [CrossRef]
- Singh, B.; Sharma, V.; Kumar, A. Designing Moringa Gum-Sterculia Gum-Polyacrylamide Hydrogel Wound Dressings for Drug Delivery Applications. Carbohydr. Polym. Technol. Appl. 2021, 2, 100062. [Google Scholar] [CrossRef]
- Fessi, H.; Puisieux, F.; Devissaguet, J.P.; Ammoury, N.; Benita, S. Nanocapsule Formation by Interfacial Polymer Deposition Following Solvent Displacement. Int. J. Pharm. 1989, 55, R1–R4. [Google Scholar] [CrossRef]
- Tim, M. Rapid Colorimetric Assay for Cellular Growth and Survival: Application to Proliferation and Cytotoxicity Assays. J. Immunol. Methods 1983, 65, 55–63. [Google Scholar] [CrossRef]
- D882-02; Standard Test Method for Tensile Properties of Thin Plastic Sheeting. ASTM International: West Conshohocken, PA, USA, 2002.
- Parodi, B.; Russo, E.; Baldassari, S.; Zuccari, G.; Yan, M.; Neduri, K.; Caviglioli, G.; Russo, E. Development and Characterization of a Mucoadhesive Sublingual Formulation for Pain Control: Extemporaneous Oxycodone Films in Personalized Therapy. Drug Dev. Ind. Pharm. 2017, 43, 917–924. [Google Scholar] [CrossRef] [PubMed]
- Osmari, B.F.; Giuliani, L.M.; Reolon, J.B.; Rigo, G.V.; Tasca, T.; Cruz, L. Gellan Gum-Based Hydrogel Containing Nanocapsules for Vaginal Indole-3-Carbinol Delivery in Trichomoniasis Treatment. Eur. J. Pharm. Sci. 2020, 151, 105379. [Google Scholar] [CrossRef] [PubMed]
- Giuliani, L.M.; Pegoraro, N.S.; Camponogara, C.; Osmari, B.F.; Brum, T. de B.; Reolon, J.B.; Rechia, G.C.; Oliveira, S.M.; Cruz, L. Locust Bean Gum Based Hydrogel Containing Nanocapsules for 3, 3 ′ -Diindolylmethane Delivery in Skin Inflammatory Conditions. J. Drug Deliv. Sci. Technol. 2022, 78, 103960. [Google Scholar] [CrossRef]
- Pereira, G.G.; Guterres, S.S.; Balducci, A.G.; Colombo, P.; Sonvico, F. Polymeric Films Loaded with Vitamin E and Aloe Vera for Topical Application in the Treatment of Burn Wounds. Biomed Res. Int. 2014, 2014, 1–9. [Google Scholar] [CrossRef]
- Re, R.; Pellegrini, N.; Proteggente, A.; Pannala, A.; Yang, N.; Rice-Evans, C. Antioxidant Activity Applying an Improved ABTS Radical Cation Decolorization Assay Roberta. Free Radic. Biol. Med. 1999, 26, 1231–1237. [Google Scholar] [CrossRef] [PubMed]
- F 756-00; Standard Practice for Assessment of Hemolytic Properties of Materials. ASTM International: West Conshohocken, PA, USA, 2020.
- Interagency Coordinating Committee on the Validation of Alternative Methods (ICCVAM) Recommended Test Method Protocol: Hen’s Egg Test—Chorioallantoic Membrane (HET-CAM) Test Method. ICCVAM Test Method Eval. Rep. 2010, 13, B30–B38.
- Swetter, S.M.; Tsao, H.; Bichakjian, C.K.; Curiel-Lewandrowski, C.; Elder, D.E.; Gershenwald, J.E.; Guild, V.; Grant-Kels, J.M.; Halpern, A.C.; Johnson, T.M.; et al. Guidelines of Care for the Management of Primary Cutaneous Melanoma. J. Am. Acad. Dermatol. 2019, 80, 208–250. [Google Scholar] [CrossRef] [PubMed]
- Beasley, G.M.; Zager, J.S.; Thompson, J.F. The Landmark Series: Regional Therapy of Recurrent Cutaneous Melanoma. Ann. Surg. Oncol. 2020, 27, 35–42. [Google Scholar] [CrossRef] [PubMed]
- Borgheti-Cardoso, L.N.; Viegas, J.S.R.; Silvestrini, A.V.P.; Caron, A.L.; Praça, F.G.; Kravicz, M.; Bentley, M.V.L.B. Nanotechnology Approaches in the Current Therapy of Skin Cancer. Adv. Drug Deliv. Rev. 2020, 153, 109–136. [Google Scholar] [CrossRef]
- Hafeez, A.; Kazmi, I. Dacarbazine Nanoparticle Topical Delivery System for the Treatment of Melanoma. Sci. Rep. 2017, 7, 1–10. [Google Scholar] [CrossRef]
- Mirzaei-mohkam, A.; Garavand, F.; Dehnad, D.; Keramat, J.; Nasirpour, A. Progress in Organic Coatings Optimisation, Antioxidant Attributes, Stability and Release Behaviour of Carboxymethyl Cellulose Fi Lms Incorporated with Nanoencapsulated Vitamin, E. Prog. Org. Coatings 2019, 134, 333–341. [Google Scholar] [CrossRef]
- Marchiori, M.C.L.; Rigon, C.; Camponogara, C.; Oliveira, S.M.; Cruz, L. Hydrogel Containing Silibinin-Loaded Pomegranate Oil Based Nanocapsules Exhibits Anti-Inflammatory Effects on Skin Damage UVB Radiation-Induced in Mice. J. Photochem. Photobiol. B Biol. 2017, 170, 25–32. [Google Scholar] [CrossRef]
- Ferreira, L.M.; Cervi, V.F.; Sari, M.H.M.; Barbieri, A.V.; Ramos, A.P.; Copetti, P.M.; de Brum, G.F.; Nascimento, K.; Nadal, J.M.; Farago, P.V.; et al. Diphenyl Diselenide Loaded Poly(ε-Caprolactone) Nanocapsules with Selective Antimelanoma Activity: Development and Cytotoxic Evaluation. Mater. Sci. Eng. C 2018, 91, 1–9. [Google Scholar] [CrossRef] [PubMed]
- Carletto, B.; Berton, J.; Ferreira, T.N.; Dalmolin, L.F.; Paludo, K.S.; Mainardes, R.M.; Farago, P.V.; Favero, G.M. Resveratrol-Loaded Nanocapsules Inhibit Murine Melanoma Tumor Growth. Colloids Surf. B Biointerfaces 2016, 144, 65–72. [Google Scholar] [CrossRef] [PubMed]
- Talkar, S.S.; Kharkar, P.B.; Patravale, V.B. Docetaxel Loaded Pomegranate Seed Oil Based Nanostructured Lipid Carriers: A Potential Alternative to Current Formulation. AAPS PharmSciTech 2020, 21, 1–11. [Google Scholar] [CrossRef]
- Pegoraro, N.S.; Mattiazzi, J.; da Silveira, E.F.; Azambuja, J.H.; Braganhol, E.; Cruz, L. Improved Photostability and Cytotoxic Effect of Coenzyme Q10 by Its Association with Vitamin E Acetate in Polymeric Nanocapsules. Pharm. Dev. Technol. 2018, 23, 400–406. [Google Scholar] [CrossRef] [PubMed]
- Yousuf, B.; Wu, S.; Gao, Y. Characteristics of Karaya Gum Based Films: Amelioration by Inclusion of Schisandra Chinensis Oil and Its Oleogel in the Film Formulation. Food Chem. 2021, 345, 128859. [Google Scholar] [CrossRef]
- Cao, T.L.; Song, K. Bin Active Gum Karaya/Cloisite Na+ Nanocomposite Films Containing Cinnamaldehyde. Food Hydrocoll. 2019, 89, 453–460. [Google Scholar] [CrossRef]
- Pagano, C.; Ceccarini, M.R.; Calarco, P.; Scuota, S.; Conte, C.; Primavilla, S.; Ricci, M.; Perioli, L. Bioadhesive Polymeric Films Based on Usnic Acid for Burn Wound Treatment: Antibacterial and Cytotoxicity Studies. Colloids Surf. B Biointerfaces 2019, 178, 488–499. [Google Scholar] [CrossRef]
- Notario-Pérez, F.; Cazorla-Luna, R.; Martín-Illana, A.; Galante, J.; Ruiz-Caro, R.; das Neves, J.; Veiga, M.D. Design, Fabrication and Characterisation of Drug-Loaded Vaginal Films: State-of-the-Art. J. Control Release 2020, 327, 477–499. [Google Scholar] [CrossRef]
- Chandra, A.; Chondkar, A.D.; Shirodkar, R.; Lewis, S.A. Rapidly Dissolving Lacidipine Nanoparticle Strips for Transbuccal Administration; Elsevier B.V.: Amsterdam, The Netherlands, 2018; Volume 47, ISBN 9449283222. [Google Scholar]
- Morales, J.O.; McConville, J.T. Manufacture and Characterization of Mucoadhesive Buccal Films. Eur. J. Pharm. Biopharm. 2011, 77, 187–199. [Google Scholar] [CrossRef]
- Irfan, M.; Rabel, S.; Bukhtar, Q.; Qadir, M.I.; Jabeen, F.; Khan, A. Orally Disintegrating Films: A Modern Expansion in Drug Delivery System. Saudi Pharm. J. 2016, 24, 537–546. [Google Scholar] [CrossRef]
- Horinaka, J.-i; Hashimoto, Y.; Takigawa, T. Optical and Mechanical Properties of Pullulan Films Studied by Uniaxial Stretching. Int. J. Biol. Macromol. 2018, 118, 584–587. [Google Scholar] [CrossRef] [PubMed]
- Gershenwald, J.E.; Scolyer, R.A.; Hess, K.R.; Sondak, V.K.; Georgina, V.; Long MBBS, G.V.; Ross, M.I.; Lazar, A.J.; Faries, M.B.; Kirkwood, J.M.; et al. Melanoma Staging: Evidence-Based Changes in the American Joint Committee on Cancer Eighth Edition Cancer. CA A Cancer J. Clin. 2017, 67, 472–492. [Google Scholar] [CrossRef] [PubMed]
- Osmałek, T.; Froelich, A.; Tasarek, S. Application of Gellan Gum in Pharmacy and Medicine. Int. J. Pharm. 2014, 466, 328–340. [Google Scholar] [CrossRef] [PubMed]
- Noronha, C.M.; De Carvalho, S.M.; Lino, R.C.; Barreto, P.L.M. Characterization of Antioxidant Methylcellulose Film Incorporated with α-Tocopherol Nanocapsules. Food Chem. 2014, 159, 529–535. [Google Scholar] [CrossRef]
- Dhal, C.; Mishra, R. In Vitro and In Vivo Evaluation of Gentamicin Sulphate-Loaded PLGA Nanoparticle-Based Film for the Treatment of Surgical Site Infection. Drug Deliv. Transl. Res. 2020, 10, 1032–1043. [Google Scholar] [CrossRef]
- Nayak, S.; Andrew Lyon, L. Soft Nanotechnology with Soft Nanoparticles. Angew. Chemie -Int. Ed. 2005, 44, 7686–7708. [Google Scholar] [CrossRef]
- Dhiman, M.; Singh, A.; Sharma, M.M. A Review on Sterculia Urens Roxb.: A Boon to the Livelihood for Tribal People and Industry. Ind. Crops Prod. 2019, 130, 341–351. [Google Scholar] [CrossRef]
- Marchiori, M.C.L.; Rigon, C.; Copetti, P.M.; Sagrillo, M.R.; Cruz, L. Nanoencapsulation Improves Scavenging Capacity and Decreases Cytotoxicity of Silibinin and Pomegranate Oil Association. AAPS PharmSciTech 2017, 18, 3236–3246. [Google Scholar] [CrossRef]
- Repka, M.A.; Gutta, K.; Prodduturi, S.; Munjal, M.; Stodghill, S.P. Characterization of Cellulosic Hot-Melt Extruded Films Containing Lidocaine. Eur. J. Pharm. Biopharm. 2005, 59, 189–196. [Google Scholar] [CrossRef]
- Zhang, L.; Alfano, J.; Race, D.; Davé, R.N. Zero-Order Release of Poorly Water-Soluble Drug from Polymeric Films Made via Aqueous Slurry Casting; Elsevier B.V.: Amsterdam, The Netherlands, 2018; Volume 117, ISBN 9735965860. [Google Scholar]
- Siepmann, J.; Peppas, N.A. Higuchi Equation: Derivation, Applications, Use and Misuse. Int. J. Pharm. 2011, 418, 6–12. [Google Scholar] [CrossRef]
- De Andrade, D.F.; Fontana, M.C.; Pohlmann, A.R.; Guterres, S.S.; Beck, R.C.R. Nanoencapsulation of Clobetasol Propionate Decreases Its Penetration to Skin Layers without Changing Its Relative Skin Distribution. J. Nanosci. Nanotechnol. 2015, 15, 875–879. [Google Scholar] [CrossRef] [PubMed]
- Sari, M.H.M.; Fulco, B.d.C.W.; Ferreira, L.M.; Pegoraro, N.S.; Brum, E.d.S.; Casola, K.K.; Marchiori, M.C.L.; de Oliveira, S.M.; Nogueira, C.W.; Cruz, L. Nanoencapsulation Potentiates the Cutaneous Anti-Inflammatory Effect of p,P′-Methoxyl-Diphenyl Diselenide: Design, Permeation, and in Vivo Studies of a Nanotechnological-Based Carrageenan Gum Hydrogel. Eur. J. Pharm. Sci. 2020, 153, 105500. [Google Scholar] [CrossRef] [PubMed]
- Li, Y.; Kong, D.; Ahmad, A.; Bao, B. Antioxidant Function of Isoflavone and 3, 3’-Diindolylmethane: Are They Important for Cancer Prevention and Therapy ? Antioxid. Redox Signal. 2013, 19, 139. [Google Scholar] [CrossRef] [PubMed]
- Leite, M.N.; Viegas, J.S.R.; Praça, F.S.G.; de Paula, N.A.; Ramalho, L.N.Z.; Bentley, M.V.L.B.; Frade, M.A.C. Ex Vivo Model of Human Skin (HOSEC) for Assessing the Dermatokinetics of the Anti-Melanoma Drug Dacarbazine. Eur. J. Pharm. Sci. 2021, 160, 105769. [Google Scholar] [CrossRef] [PubMed]
- Scarfì, F.; Patrizi, A.; Veronesi, G.; Lambertini, M.; Tartari, F.; Mussi, M.; Melotti, B.; Dika, E. The Role of Topical Imiquimod in Melanoma Cutaneous Metastases: A Critical Review of the Literature. Dermatol. Ther. 2020, 33, e14165. [Google Scholar] [CrossRef] [PubMed]
- Singh, B.; Kumar, A. Synthesis and Characterization of Alginate and Sterculia Gum Based Hydrogel for Brain Drug Delivery Applications. Int. J. Biol. Macromol. 2020, 148, 248–257. [Google Scholar] [CrossRef]
- Silva, S.C.C.C.; de Araujo Braz, E.M.; de Amorim Carvalho, F.A.; de Sousa Brito, C.A.R.; Brito, L.M.; Barreto, H.M.; da Silva Filho, E.C.; da Silva, D.A. Antibacterial and Cytotoxic Properties from Esteri Fi Ed Sterculia Gum. Int. J. Biol. 2020, 164, 606–615. [Google Scholar] [CrossRef]
- Bahulkar, S.S.; Munot, N.M.; Surwase, S.S. Synthesis, Characterization of Thiolated Karaya Gum and Evaluation of Effect of PH on Its Mucoadhesive and Sustained Release Properties. Carbohydr. Polym. 2015, 130, 183–190. [Google Scholar] [CrossRef]

| Free DIM | NC-B | NC-DIM | |
|---|---|---|---|
| pH | - | 4.8 ± 0.1 | 4.8 ± 0.1 |
| Particle size (nm) | - | 157 ± 2 | 154 ± 1 |
| Polydispersity index | - | 0.07 ± 0.01 | 0.07 ± 0.00 |
| Zeta potential (mV) | - | −45.0 ± 2.0 | −54.0 ± 6.0 |
| DIM content (mg/mL) | - | - | 0.96 ± 0.03 |
| Encapsulation efficiency (%) | - | - | 97.0 ± 1.0 |
| A-375 cells IC50 (µg/mL) | >24 | >24 | 2.89 |
| F-Vehicle | F-DIM | F-NC-B | F-NC-DIM | |
|---|---|---|---|---|
| Weight homogeneity (mg/cm2) | 18.3 ± 0.4 | 48.8 ± 0.9 | 21.6 ± 1.2 | 21.2 ± 0.7 |
| Drug content homogeneity (µg/cm2) | - | 101.5 ± 1.8 | - | 105.6 ± 1.6 |
| Thickness (µm) | 208 ± 29 | 480 ± 12 + | 210 ± 12 | 178 ± 22 |
| Particle size (nm) | 504 ± 142 | - | 326 ± 51 * | 326 ± 43 * |
| Polydispersity index | 0.6 ± 0.2 | - | 0.5 ± 0.1 | 0.5 ± 0.1 |
| Swelling index (%) | 809 ± 66 | 284 ± 25 + | 776 ± 21 | 768 ± 49 |
| Water contact angle (karaya gum layer) | 74.6 ± 22.3 | 42.3 ± 5.1 * | 40.7 ± 3.2 * | 32.7 ± 4.6 * |
| Water contact angle (gellan gum layer) | 42.3 ± 9.9 | 9.8 ± 4.7 + | 30.1 ± 4.5 | 30.7 ± 2.3 |
| Tensile strength (MPa) | 2.9 ± 0.80 | 0.9 ± 0.25 + | 2.6 ± 0.62 | 3.5 ± 0.47 |
| Elongation (%) | 5.3 ± 1.9 | 5.6 ± 1.4 | 3.3 ± 0.4 | 6.0 ± 1.1 |
| Young’s modulus (MPa) | 59.3 ± 22.3 | 16.5 ± 6.01 + | 78.5 ± 18.9 | 58.9 ± 2.66 |
| Mathematical Models | F-DIM | F-NC-DIM |
|---|---|---|
| Zero order | 0.9020 | 0.9694 |
| First order | 0.7157 | 0.8299 |
| Second order | 0.5068 | 0.6355 |
| Higuchi model | 0.9748 | 0.9969 |
Disclaimer/Publisher’s Note: The statements, opinions and data contained in all publications are solely those of the individual author(s) and contributor(s) and not of MDPI and/or the editor(s). MDPI and/or the editor(s) disclaim responsibility for any injury to people or property resulting from any ideas, methods, instructions or products referred to in the content. |
© 2023 by the authors. Licensee MDPI, Basel, Switzerland. This article is an open access article distributed under the terms and conditions of the Creative Commons Attribution (CC BY) license (https://creativecommons.org/licenses/by/4.0/).
Share and Cite
Reolon, J.B.; Saccol, C.P.; Osmari, B.F.; Oliveira, D.B.d.; Prado, V.C.; Cabral, F.L.; da Rosa, L.S.; Rechia, G.C.; Leal, D.B.R.; Cruz, L. Karaya/Gellan-Gum-Based Bilayer Films Containing 3,3′-Diindolylmethane-Loaded Nanocapsules: A Promising Alternative to Melanoma Topical Treatment. Pharmaceutics 2023, 15, 2234. https://doi.org/10.3390/pharmaceutics15092234
Reolon JB, Saccol CP, Osmari BF, Oliveira DBd, Prado VC, Cabral FL, da Rosa LS, Rechia GC, Leal DBR, Cruz L. Karaya/Gellan-Gum-Based Bilayer Films Containing 3,3′-Diindolylmethane-Loaded Nanocapsules: A Promising Alternative to Melanoma Topical Treatment. Pharmaceutics. 2023; 15(9):2234. https://doi.org/10.3390/pharmaceutics15092234
Chicago/Turabian StyleReolon, Jéssica Brandão, Camila Parcianello Saccol, Bárbara Felin Osmari, Daiane Britto de Oliveira, Vinicius Costa Prado, Fernanda Licker Cabral, Lucas Saldanha da Rosa, Giancarlo Cervo Rechia, Daniela Bitencourt Rosa Leal, and Letícia Cruz. 2023. "Karaya/Gellan-Gum-Based Bilayer Films Containing 3,3′-Diindolylmethane-Loaded Nanocapsules: A Promising Alternative to Melanoma Topical Treatment" Pharmaceutics 15, no. 9: 2234. https://doi.org/10.3390/pharmaceutics15092234
APA StyleReolon, J. B., Saccol, C. P., Osmari, B. F., Oliveira, D. B. d., Prado, V. C., Cabral, F. L., da Rosa, L. S., Rechia, G. C., Leal, D. B. R., & Cruz, L. (2023). Karaya/Gellan-Gum-Based Bilayer Films Containing 3,3′-Diindolylmethane-Loaded Nanocapsules: A Promising Alternative to Melanoma Topical Treatment. Pharmaceutics, 15(9), 2234. https://doi.org/10.3390/pharmaceutics15092234

